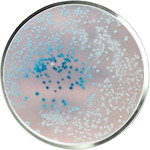
Probiotics Skincare

Probiotics
Benefits: Balances the microbiome, strengthens, and soothes the skin.
Helps: Ideal for acne, eczema, and sensitive skin - calms and protects.
Probiotics in skincare help balance your skin’s microbiome, strengthening its natural defenses while reducing inflammation. They’re perfect for soothing sensitive skin, treating acne, eczema, and rosacea, and restoring a healthy glow. By promoting a balanced pH, probiotics keep your complexion calm, clear, and resilient. Discover probiotic-infused skincare for healthier skin today.
- ProBiotic Day Cream SPF 15 | Unstress 50ml/1.7FL.OZ.
Christina ☆ Professional Cosmetics
Special Price $82.50 Regular Price $97.00 - ProBiotic Eye and Neck Day Cream SPF 12 | Unstress 30ml/1FL.OZ.
Christina ☆ Professional Cosmetics
Special Price $82.00 Regular Price $96.50 - Probiotic Mask | Texture 50ml/1.7FL.OZ.
GIGI ☆ Professional Cosmetics
Special Price $57.50 Regular Price $68.00














Login and Registration Form